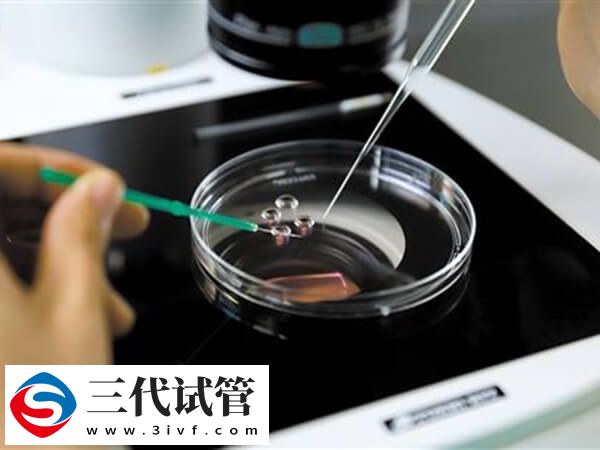
精子活力低做试管怎么办(图2)

精子活力低做试管怎么办
在试管治疗中,对于精子活力低的患者来说,可能会面临一些挑战,但通过适当的医疗干预和生活方式调整,仍然有提供试管移植的成功率。一般建议患者可通过戒烟限酒,避免熬夜,保持充足的睡眠等行为,或是适度运动,如慢跑、游泳等,可以提高身体素质,从而提高精子的质量,进而可提高胚胎的着床率。

精子活力低做试管婴儿的改善措施
试管婴儿已成为许多不孕症夫妇的希望,然而,一些夫妇可能会面临一些不利因素,如男性精子活力低或弱精症等问题,这些都可能会影响试管婴儿的成功率。因此,对于这些情况,需要采取一些有效措施来提高成功率。
1、采取良好的生活习惯
良好的生活习惯对于精子质量的提高至关重要。建议男性减少饮酒和吸烟的频率,保持充足的睡眠和锻炼身体。此外,保持平衡的饮食也是非常重要的。多吃一些富含维生素和矿物质的食物,如绿色蔬菜、鱼类和坚果等,可以帮助提高精子质量。
2、进行精液分离术
精液分离术是一种通过离心等方法分离出好的精子来提高受精率的方法。尽管精液分离术并不保证试管婴儿的成功率,但在一些特定的情况下,如精子活力低的情况下,精液分离术可以提高受精率。
3、采用ICSI技术
ICSI(单精子注射)是一种在人工授精过程中,将单个精子注入到卵子中的技术。对于弱精症的情况下,ICSI技术可以大大提高着床率和妊娠率。而且,ICESI技术也可以帮助精子活力低的男性实现成功的试管婴儿。
对于精子活力低和弱精症的情况,可以采取一些有效的措施来提高试管婴儿的成功率,如良好的生活习惯、精液分离术和ICSI技术。如果男性夫妇有这些问题,需要及时咨询医生并选择合适的方法来提高试管成功率。
精子活力低做试管婴儿的成功率
精子活力低在尝试试管婴儿时可能会面临一些挑战,但通过适当的医疗干预和生活方式调整,仍然有机会实现生育。同时针对不同精子活力低的患者,其成功率是有所差异的,如下所示:
- 轻度弱精症:成功率通常在 40%-60% 之间;
- 中度弱精症:成功率约为 30%-40%;
- 重度弱精症:成功率较低,通常在 20%-30% 之间。
虽然精子活力低可能会对试管婴儿的成功率产生一定影响,但通过综合管理和适当的医疗干预,仍有可能实现生育愿望。





